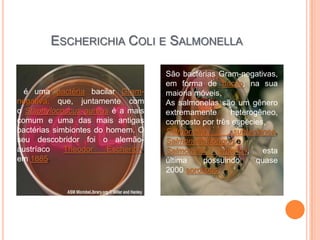
ESCHERICHIA COLI E SALMONELLA
é uma bactéria bacilar Gram-
negativa, que, juntamente com
o Staphylococcus aureus é a mais
comum e uma das mais antigas
bactérias simbiontes do homem. O
seu descobridor foi o alemão-
austríaco Theodor Escherich,
em 1885.
São bactérias Gram-negativas,
em forma de bacilo, na sua
maioria móveis,
As salmonelas são um gênero
extremamente heterogêneo,
composto por três espécies,
Salmonella subterranea,
Salmonella bongori e
Salmonella enterica, esta
última possuindo quase
2000 sorotipos

O documento discute Enterobactérias como E. coli e Salmonella, incluindo suas características, formas de contaminação e transmissão, sintomas e tratamento. E. coli geralmente faz parte da microbiota intestinal humana, enquanto Salmonella pode causar intoxicação alimentar através de alimentos contaminados. Os principais sintomas incluem diarreia e cólicas abdominais, e a prevenção envolve boa higiene e cuidados com alimentos.